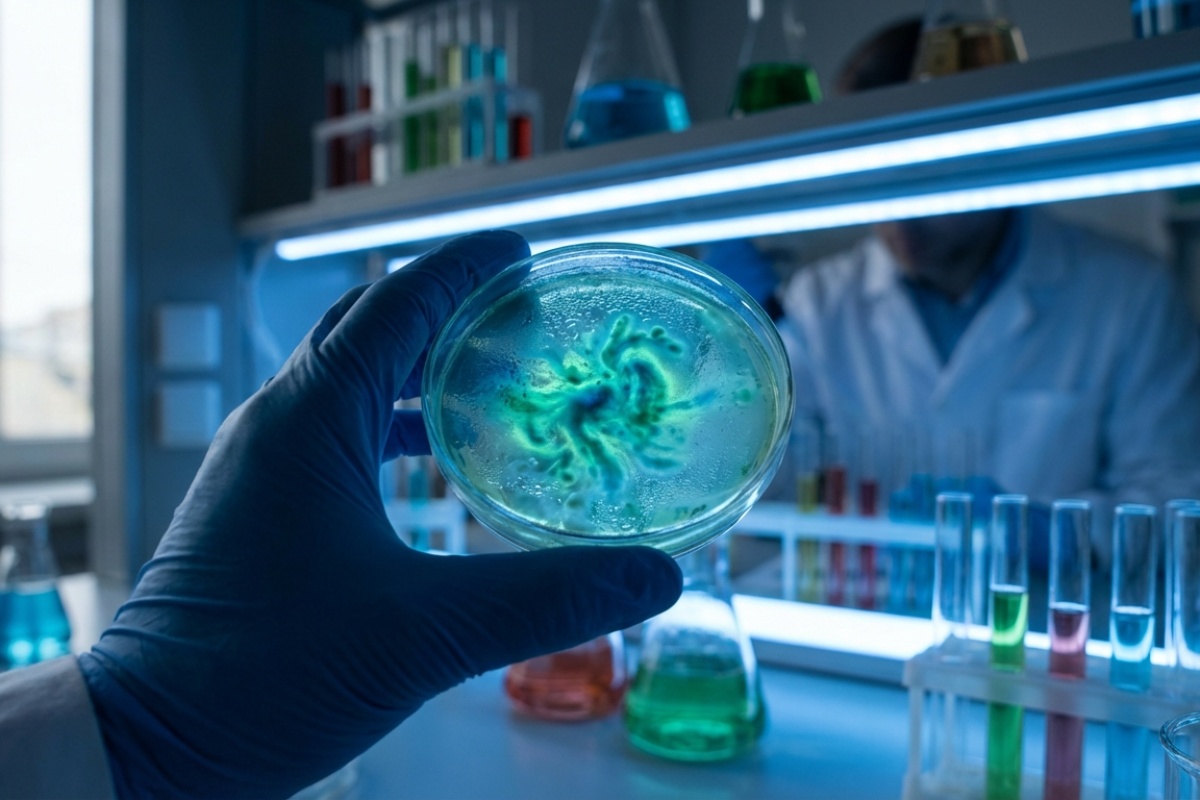
Istraživači ne mogu vjerovati: pronađene tisuće novih mikrobnih vrsta u izmetu raznih biljojeda detail 1

Na visoravni Qinghai-Tibet, tim znanstvenika otkrio je iznenađujući i dosad nepoznat ’mikrobni svemir’ skriven na najmanje očekivanom mjestu: u izmetu velikih lokalnih biljojeda. Ovo fascinantno istraživanje otvara vrata potpuno novom razumijevanju mikrobiologije u ekstremnim uvjetima.
Studija, nedavno objavljena u prestižnom časopisu Microbiome, otkriva zapanjujući podatak da čak 88% mikrobnih vrsta pronađenih u uzorcima jaka, tibetanske ovce, antilope, goveda, konja i kianga (divljeg magarca) nikada prije nije bilo katalogizirano. Ovo otkriće ne samo da proširuje naše znanje o biološkoj raznolikosti, već otvara i nove, revolucionarne prilike za biotehnologiju, farmakologiju i borbu protiv klimatskih promjena.
Masivno otkriće novih vrsta na 'krovu svijeta’
Ovaj znanstveni poduhvat dio je opsežnog Drugog programa znanstvene ekspedicije i istraživanja tibetanske visoravni. Riječ je o inicijativi koja je tijekom pet godina prikupila više od 5.000 fekalnih uzoraka od šest vrsta autohtonih biljojeda koji su se prilagodili životu na velikim nadmorskim visinama: jakova, tibetanskih ovaca, antilopa, stoke, konja i kianga.
Početna analiza, koju su proveli stručnjaci iz BGI-Research i Sveučilišta Yunnan, fokusirala se na 1.412 svježe prikupljenih uzoraka. Rezultati su nadmašili sva predviđanja znanstvene zajednice. Činjenica da gotovo devet od deset identificiranih mikrobnih vrsta nije bilo poznato znanosti sugerira da ovi ekosustavi kriju ogromne biološke tajne.
Prvi iscrpan uvid u mikrobiom visoke planine
Glavni autor studije, Zhang Zhigang, istaknuo je za South China Morning Post (SCMP) kako ova novostvorena baza podataka nudi prvi sveobuhvatan uvid u crijevni mikrobiom sisavaca koji žive u ekstremnim uvjetima visoke planine.
Osim znanstvene znatiželje, Zhang je naglasio i stratešku vrijednost otkrića. Mnoge od ovih bioloških funkcija mogle bi postati patentibilna imovina u sve većoj globalnoj utrci za genomskim resursima. U svijetu gdje se traže novi biološki alati, tibetanska visoravan mogla bi postati rudnik zlata za genetičare.
Biotehnološki potencijal i industrijska primjena
Osim ekološke važnosti, mikroorganizmi otkriveni u izmetu predstavljaju obećavajući izvor za inovacije u genetskom inženjeringu i farmakologiji. Znanstvenici su posebno uzbuđeni zbog specifičnih genetskih alata koje ovi mikrobi posjeduju.
- Novi alati za uređivanje gena: Istraživači su istaknuli da bi među novootkrivenim genima mogli postojati enzimi s funkcijama sličnim onima koje podržavaju sustav CRISPR-Cas, ključan za rezanje i uređivanje DNK s visokom preciznošću. Mogućnost pronalaska stabilnijih ili učinkovitijih varijanti otvara opcije za naprednije tehnologije uređivanja gena.
- Farmaceutska revolucija: U farmaceutskom području, otkrivena mikrobna raznolikost uključuje molekule koje bi se mogle pretvoriti u nove antimikrobne lijekove ili terapijske spojeve, detaljno navodi SCMP.

Nove mikrobne staze za smanjenje metana i razgradnju celuloze
Projekt također naglašava izravne primjene za smanjenje emisija stakleničkih plinova korištenjem mikrobioma biljojeda s visokih planina. Ovo su neka od najistaknutijih otkrića koja bi mogla pomoći planetu:
- Učinkovita razgradnja celuloze: Budući da ovi biljojedi konzumiraju žilave, vlaknaste biljke, njihov probavni sustav favorizira prisutnost enzima specijaliziranih za razgradnju celuloze. Tim trenutno provodi testove kako bi procijenio mogu li se ovi sojevi koristiti u industrijama poput proizvodnje papira ili tekstila, čineći procese učinkovitijima.
- Bakterije koje smanjuju metan: Studija je identificirala dvije dosad nepoznate bakterijske vrste u izmetu koje su, u testovima fermentacije in vitro, uspjele značajno smanjiti emisije metana u usporedbi s kontrolnim skupinama. Istraživači sada pripremaju eksperimente kako bi potvrdili ove rezultate na živim životinjama.
Ovaj napredak mogao bi pretvoriti visoravan Qinghai-Tibet u globalnu referentnu točku za biološka rješenja usmjerena na borbu protiv globalnog zatopljenja. U teritoriju gdje uspijevaju samo organizmi koji su se izvanredno prilagodili, znanstvenici su pronašli funkcionalnu rezervu s kapacitetom da transformira biotehnologiju i industriju u nadolazećim godinama.
